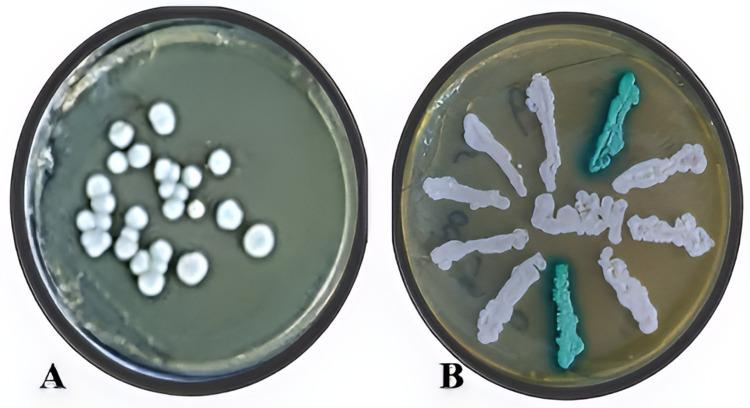
https://cdn.ncbi.nlm.nih.gov/pmc/blobs/460a/12275016/67fe4114a60c/CCIDE-17-285-g0001.jpg
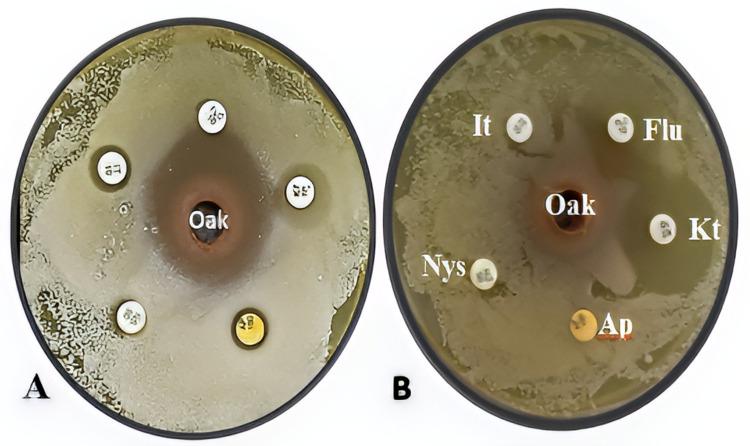
https://cdn.ncbi.nlm.nih.gov/pmc/blobs/460a/12275016/77dd5655efa5/CCIDE-17-285-g0004.jpg

树皮对由儿科口腔感染引起并分离出的口腔念珠菌病的影响,与唑类抗真菌药的比较
The Effect of Bark on Oral Candidiasis Caused by and Isolated from a Pediatric Oral Infection as Comparison to Azole Antifungal.
作者信息
Naji Sura Sabah, Mahmood Maha Abdul-Kareem, Hussein Hashim Mueen, Mahmood Athraa Ali, Baker Hayder Sadiq
机构信息
Department of Oral Pathology, College of Dentistry, Mustansiriyah University, Baghdad, Iraq.
Department of Orthodontics, Pedodontics and Preventive Dentistry, College of Dentistry, Mustansiriyah University, Baghdad, Iraq.
出版信息
Clin Cosmet Investig Dent. 2025 Jul 14;17:285-292. doi: 10.2147/CCIDE.S527034. eCollection 2025.
BACKGROUND
The original diversity of L. (oak) is in eastern America and then distributed to European districts. Oral candidiasis is the most common fungal infection among humans. Azole antifungal drugs can be used to treat Candida infection. and have emerged as the most common pathogenic yeasts in cases of oral candidiasis.
AIM OF THE STUDY
This study aimed to explore the genotype spp. and evaluate the antifungal activity of hot water extract of oak bark against and as an alternative pharmacotherapy compared to azole antifungal agents.
MATERIALS AND METHODS
The sample was isolated from an 8-year-old child with aggressive oral candidiasis and identified by culturing on sabouraud dextrose agar (SDA) CHROMagar. Genotyping of spp. was performed using the internal transcribed spacer (ITS) region. Standard discs of the antifungal's fluconazole, itraconazole, ketoconazole 10 mg/L for each, amphotericin 100, nystatin 50 mg/L, and hot water oak bark extract were administered to and in vitro.
RESULTS
Genotyping of spp. showed that 98% of oral candidiasis cases were which had an 870 bp genotype, while 2% were which had a 550 bp genotype based on ITS barcoding region size. The findings that the oak bark extract had high antifungal activity against showed an inhibition zone diameter of 3.067 mm compared to high resistance to antifungals.
CONCLUSION
Oak extract is considered a successful alternative for the treatment of oral candidiasis infections by antifungals such as azole and nystatin in children.
背景
L.(橡木)最初的多样性存在于美国东部,然后分布到欧洲地区。口腔念珠菌病是人类中最常见的真菌感染。唑类抗真菌药物可用于治疗念珠菌感染。白色念珠菌和热带念珠菌已成为口腔念珠菌病病例中最常见的致病酵母。
研究目的
本研究旨在探索白色念珠菌属的基因型,并评估橡木树皮热水提取物对白色念珠菌和热带念珠菌的抗真菌活性,作为与唑类抗真菌剂相比的替代药物疗法。
材料与方法
样本取自一名患有侵袭性口腔念珠菌病的8岁儿童,通过在沙保弱葡萄糖琼脂(SDA)CHROMagar上培养进行鉴定。使用内转录间隔区(ITS)区域对白色念珠菌属进行基因分型。将抗真菌药氟康唑、伊曲康唑、酮康唑的标准圆盘各10mg/L、两性霉素100、制霉菌素50mg/L以及橡木树皮热水提取物在体外施用于白色念珠菌和热带念珠菌。
结果
白色念珠菌属的基因分型显示,基于ITS条形码区域大小,98%的口腔念珠菌病病例为白色念珠菌,其基因型为870bp,而2%为热带念珠菌,其基因型为550bp。橡木树皮提取物对白色念珠菌具有高抗真菌活性的结果显示,与对抗真菌药的高抗性相比,抑菌圈直径为3.067mm。
结论
橡木提取物被认为是治疗儿童口腔念珠菌病感染的一种成功替代方法,可替代唑类和制霉菌素等抗真菌药物。